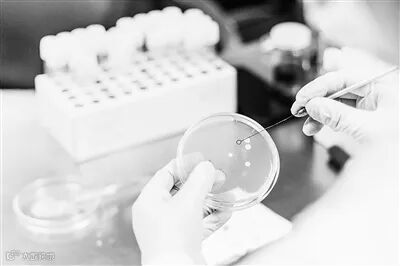

微生物学家在实验室进行细菌测试。
◎本报记者 陈 曦
“细菌也能直接放电”听起来似乎匪夷所思,但这一相关领域的研究已有百年历史。产电菌是电活性微生物的一种,它们在微生物电子传递过程中发挥着巨大作用,不断刷新人们对微生物能量代谢过程的认知。如今,很多污染物预警和快速降解、能源回收、贵金属提取等领域的“黑科技”,灵感和基础都来自于它们。
日前,天津大学化工学院教授宋浩团队在《定量生物学》刊文,回顾了以细胞色素和导电纳米线为核心的导电蛋白质,在微生物电子传递过程中发挥的关键作用。文章展望了细胞色素和导电纳米线未来潜在研究方向,为推动电活性微生物实际应用提供了参考。
可与外界环境双向交换电子的特殊微生物
“能够与外界环境进行双向电子交换的微生物,被称为电活性微生物。其中包括向外界环境释放电子的产电活性微生物,以及从外界环境获取电子的噬电活性微生物。”宋浩介绍。
早在1910年,英国科学家马克·比特就发现,微生物的培养液能够产生电流。此后,研究人员相继挖掘、筛选、鉴定了多种产电活性微生物。其中,对于兼性厌氧菌奥奈达希瓦氏菌和严格厌氧菌硫还原地杆菌的研究最为广泛。在21世纪初,研究人员对这两种模式产电菌先后完成了基因测序,使得人们对产电活性微生物的遗传背景有了进一步认识。
这类产电活性微生物是如何施展产电“超能力”的呢?“发电的本质是能量转换。”宋浩介绍,在生物体内,底物有机质在细胞呼吸作用中被氧化,释放的电子通过细胞呼吸链传递、转移。一个葡萄糖分子在生物体内完全氧化后,可以产生多达24个电子。
宋浩进一步解释,产电活性微生物的能量释放不仅局限于细胞内,它们还可以进行胞外电子转移。产电活性微生物通过细胞膜上内嵌的导电蛋白和电子传递载体,以及从细胞膜生长出来的导电纳米线,把氧化环境中有机物产生的电子传递给环境中的电子受体。
近10年来,研究人员又逐渐发现一些电活性微生物能够从氢气、电极等电子供体噬取电子,用于维持细胞生长。这类电活性微生物被命名为噬电活性微生物,主要包括热莫尔氏菌、罗尔斯通菌、乙醇梭菌、沼泽红假单胞菌以及鼠胞菌等。
在诸多领域展现出应用潜力
宋浩介绍,电活性微生物在能源、化工和医疗等诸多领域展现出巨大的应用潜力。
产电活性微生物可将有机物降解并释放电子,实现化学能到电能的转化。因此,产电活性微生物可利用环境、污水中的有机质发电,也可利用释放的电子还原金属阳离子来制备金属纳米材料,为解决能源不足、推动绿色先进制造提供方案。
宋浩举例说,太阳能电池、热电装置和机械发电机大多对使用环境有要求。但新开发的基于导电蛋白利用大气水分实现能量收集的蛋白质纳米线薄膜发电机,可以产生至少20小时的连续电流。而且相比于其他可持续电力生成系统,这种装置受位置或环境条件的限制更少。
基于产电活性微生物的产电原理,“电池家族”也有望增加新成员。用于生物降解有机废物同时收集电能的微生物燃料电池、可以产氢气的微生物电解电池、用于海水淡化的微生物脱盐电池等,都是科研人员正在努力的研发方向。
另一方面,噬电活性微生物可以利用噬取的电子,驱动细胞物质合成,实现从电能到化学能的转化。它们可以将二氧化碳等低能量密度、高氧化态的底物,还原为高级醇、脂肪酸等高能量密度、高还原态的高值化学品,为实现“双碳”目标建立技术途径。
走向产业化仍面临多重挑战
近年来,以电活性微生物为催化核心的生物电化学系统在全球范围内正逐渐步入产业化应用,某些领域已初具产业规模。
在产电活性微生物的利用方面,国际上已有多家科技企业,利用产电活性微生物开发微生物燃料电池系统,用于污水处理与电能回收。
而对于噬电活性微生物的利用,光电驱动噬电活性微生物固氮固碳合成高值化学品技术成了当今投资界的新宠。例如美国公司开发了仿生叶片装置,利用太阳能电池板提供电力,把水分解为氢气和氧气。噬电活性微生物自养黄杆菌以氢气为电子供体固碳固氮合成液态肥料。
“尽管电活性微生物展示出巨大的应用潜力,但其应用仍面临着科学、工程、经济和社会等多个层面的挑战。”宋浩说。
天津大学化工学院副研究员李锋认为,天然存在的野生型产电活性微生物的胞外电子传递速率低,严重限制了电活性微生物的能量转化效率。这是阻碍其广泛工业化应用的核心瓶颈。
在噬电活性微生物的应用上,天津大学化工学院副教授曹英秀介绍,噬电细胞主要通过从胞外电极上获取电子并转化为自身还原力来驱动化学品合成,该过程包括胞外电子跨膜传递—胞内还原力转化—产物定向合成。其中,电子跨膜传递速率慢、跨膜电子到胞内还原力转化效率低是制约噬电活性微生物应用的重要因素。
此外,宋浩认为,目前部分高效电活性微生物的生物安全性尚未得到充分论证,电活性微生物的工业应用可能涉及到法规和伦理问题。尤其是在食品、医学、农业和环境领域,需要确保新技术的安全性、可持续性,并符合相关法规和伦理标准。
“生物电化学系统相关产业仍处于初始发展阶段,尚未形成完整的产业链,生产研发成本居高不下,产业经济效益不够突出。要克服这些瓶颈,未来还需要多学科的共同努力。”宋浩说。
转载自2024年2月21日《科技日报》06版生物


